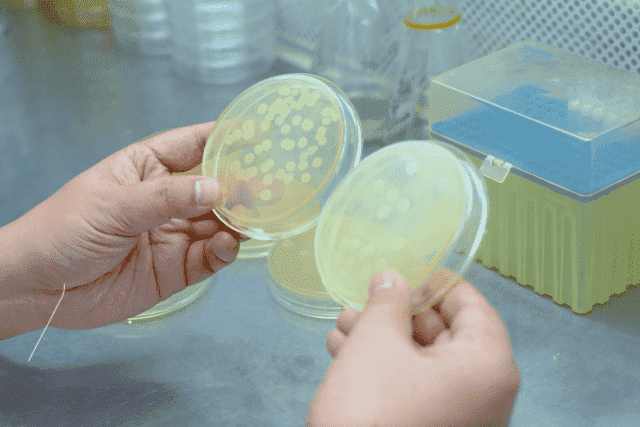
Application and Substitution Strategy of Animal-Free Peptones in Industrial Fermentation

AngeoPro?, ein innovatives und hochmodernes fermentiertes Hefeprotein, entwickelt von Angel Yeast, steht an der Spitze der Proteinrevolution. Durch die Nutzung der Kraft von Saccharomyces cerevisiae liefert AngeoPro au?ergew?hnliche Proteinqualit?t, Leistung und Skalierbarkeit.